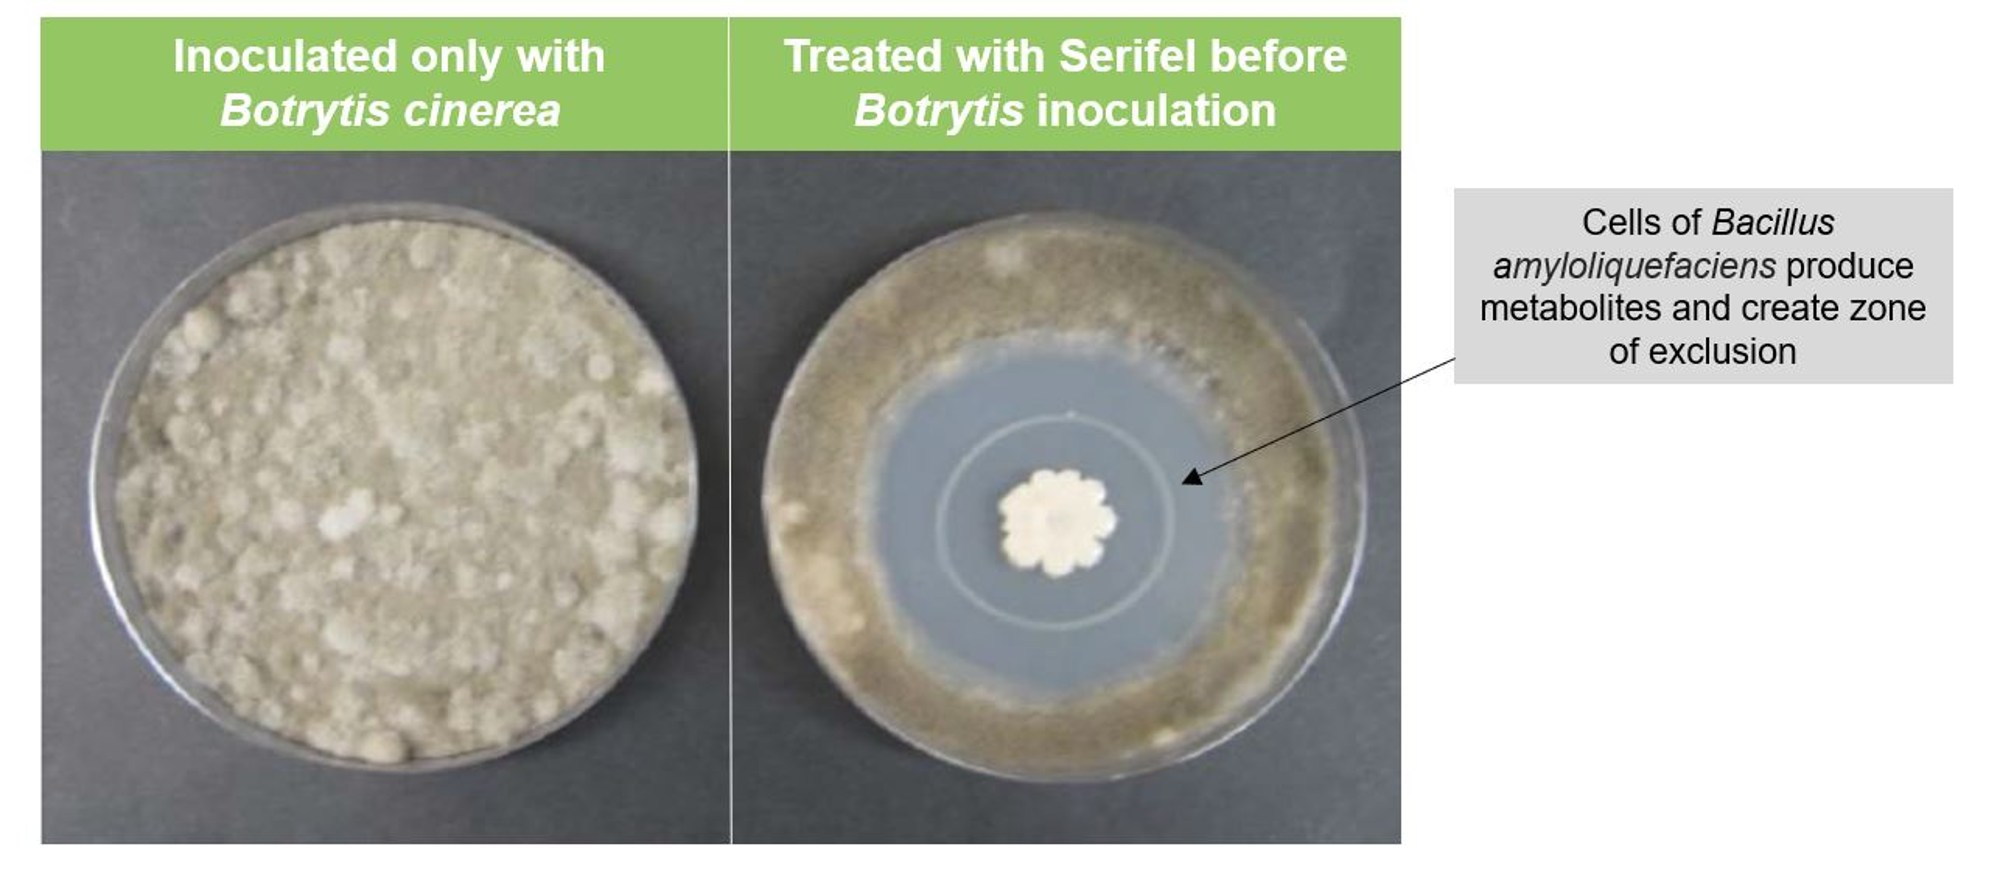

Serifel® is a protectant biological fungicide for the reduction of fruit damage caused by Botrytis cinerea (grey mould) in protected strawberries, raspberries, blackberries, blueberries, loganberries and Rubus hybrid; the moderate control of Botrytis cinerea in protected tomatoes, aubergines, pepper and chilli pepper and the moderate control of Botrytis cinerea and Sclerotinia species in protected lettuce and other leafy crops.
Serifel®
Serifel® is a protectant biological fungicide for the reduction of fruit damage caused by Botrytis cinerea (grey mould) in protected strawberries, raspberries, blackberries, blueberries, loganberries and Rubus hybrid; the moderate control of Botrytis cinerea in protected tomatoes, aubergines, pepper and chilli pepper and the moderate control of Botrytis cinerea and Sclerotinia species in protected lettuce and other leafy crops.
Benefits
- Residue-free solution which allows for greater flexibility in application throughout the growing cycle
- Rainfast within 3 hours of application
- IPM compatible (safe on predatory mites Amblyseius swirskii, Phytoseiulus persimilis; the predatory bug Nesidiocoris tenuis and the parasitoids Diglyphus isaea and Eretmocerus eremicus)
| Label | |
|---|---|
| Safety data sheet | |
| BASF Compatibility List |




_2000w.jpg?1678992832071)